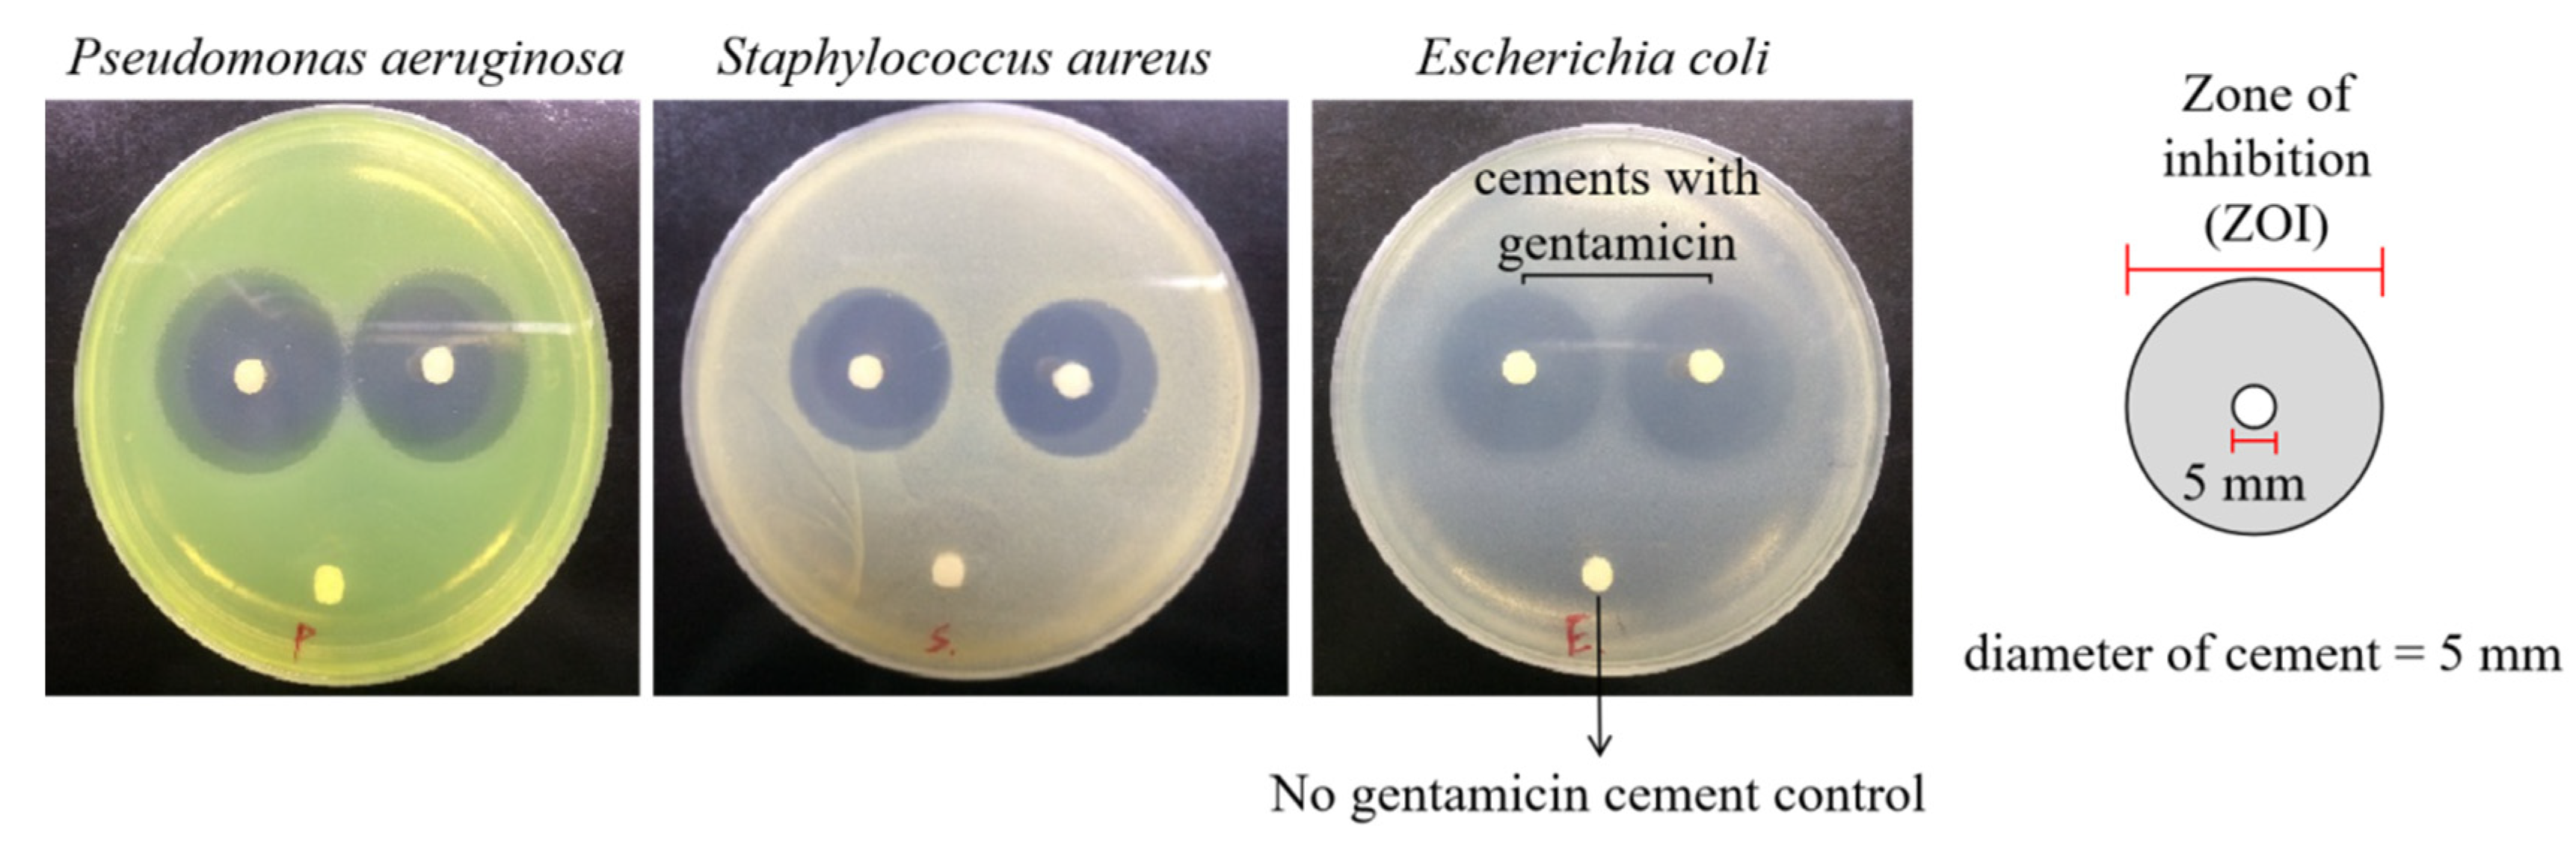
Polymers 13 02240 g001 Polymers 13 02240 g001

Influence of Antibiotic-Loaded Acrylic Bone Cement Composition on Drug Release Behavior and Mechanism
Abstract
1. Introduction
2. Materials and Methods
2.1. Material Composition and Mixing Procedure
2.2. Scanning Electronic Microscopy Imaging
2.3. Cell Viability
2.4. Mechanical Compression Testing
2.5. Bioassay of Antibiotic Activity
2.6. Porosity and Pore Size Distribution
2.7. Antibiotic Elution
3. Results
3.1. PMMA Bone Cement Composite and Antibacterial Properties
3.2. Effects of Liquid/Powder Ratio on Antibiotic Elution
3.3. Effects of Radiopacifier Ratio on Antibiotic Elution
3.4. Effects of Initiator Ratio on Antibiotic Elution
3.5. Effects of Antibiotic Doses on Antibiotic Elution
4. Discussion
5. Conclusions
Author Contributions
Funding
Institutional Review Board Statement
Informed Consent Statement
Data Availability Statement
Conflicts of Interest
References
- Kurtz, S.; Ong, K.; Lau, E.; Mowat, F.; Halpern, M. Projections of primary and revision hip and knee arthroplasty in the United States from 2005 to 2030. J. Bone Jt. Surg. 2007, 89, 780–785. [Google Scholar] [CrossRef]
- Dobson, P.F.; Reed, M.R. Prevention of infection in primary THA and TKA. EFORT Open Rev. 2020, 5, 604–613. [Google Scholar] [CrossRef] [PubMed]
- Sharkey, P.F.; Lichstein, P.M.; Shen, C.; Tokarski, A.T.; Parvizi, J. Why are total knee arthroplasties failing today—Has anything changed after 10 years? J. Arthroplast. 2014, 29, 1774–1778. [Google Scholar] [CrossRef]
- Bistolfi, A.; Massazza, G.; Verné, E.; Massè, A.; Deledda, D.; Ferraris, S.; Miola, M.; Galetto, F.; Crova, M. Antibiotic-Loaded Cement in Orthopedic Surgery: A Review. ISRN Orthop. 2011, 2011, 290851. [Google Scholar] [CrossRef]
- Armstrong, M.; Spencer, R.F.; Lovering, A.M.; Gheduzzi, S.; Miles, A.W.; Learmonth, I.D. Antibiotic elution from bone cement: A study of common cement-antibiotic combinations. Hip Int. 2002, 12, 23–27. [Google Scholar] [CrossRef]
- Parvizi, J.; Saleh, K.J.; Ragland, P.S.; Pour, A.E.; Mont, M.A. Efficacy of antibiotic-impregnated cement in total hip replacement. Acta Orthop. 2008, 79, 335–341. [Google Scholar] [CrossRef] [PubMed]
- Chang, Y.H.; Tai, C.L.; Hsu, H.Y.; Hsieh, P.H.; Lee, M.S.; Ueng, S.W. Liquid antibiotics in bone cement: An effective way to improve the efficiency of antibiotic release in antibiotic loaded bone cement. Bone Jt. Res. 2014, 3, 246–251. [Google Scholar] [CrossRef]
- Lee, S.H.; Tai, C.L.; Chen, S.Y.; Chang, C.H.; Chang, Y.H.; Hsieh, P.H. Elution and Mechanical Strength of Vancomycin-Loaded Bone Cement: In Vitro Study of the Influence of Brand Combination. PLoS ONE 2016, 11, e0166545. [Google Scholar] [CrossRef] [PubMed]
- Salehi, A.; Parker, A.C.; Lewis, G.; Courtney, H.S.; Haggard, W.O. A daptomycin-xylitol-loaded polymethylmethacrylate bone cement: How much xylitol should be used? Clin. Orthop. Relat. Res. 2013, 471, 3149–3157. [Google Scholar] [CrossRef][Green Version]
- Wall, V.; Nguyen, T.H.; Nguyen, N.; Tran, P.A. Controlling Antibiotic Release from Polymethylmethacrylate Bone Cement. Biomedicines 2021, 9, 26. [Google Scholar] [CrossRef] [PubMed]
- Perni, S.; Caserta, S.; Pasquino, R.; Jones, S.A.; Prokopovich, P. Prolonged Antimicrobial Activity of PMMA Bone Cement with Embedded Gentamicin-Releasing Silica Nanocarriers. ACS Appl. Bio Mater. 2019, 2, 1850–1861. [Google Scholar] [CrossRef]
- Raza, F.; Zafar, H.; Zhu, Y.; Ren, Y.; Ullah, A.; Khan, A.U.; He, X.; Han, H.; Aquib, M.; Boakye-Yiadom, K.O.; et al. A Review on Recent Advances in Stabilizing Peptides/Proteins upon Fabrication in Hydrogels from Biodegradable Polymers. Pharmaceutics 2018, 10, 16. [Google Scholar] [CrossRef] [PubMed]
- Shen, S.C.; Ng, W.K.; Dong, Y.C.; Ng, J.; Tan, R.B. Nanostructured material formulated acrylic bone cements with enhanced drug release. Mater. Sci. Eng. C Mater. Biol. Appl. 2016, 58, 233–241. [Google Scholar] [CrossRef] [PubMed]
- Wu, X.; Li, Y.; Raza, F.; Wang, X.; Zhang, S.; Rong, R.; Qiu, M.; Su, J. Red Blood Cell Membrane-Camouflaged Tedizolid Phosphate-Loaded PLGA Nanoparticles for Bacterial-Infection Therapy. Pharmaceutics 2021, 13, 99. [Google Scholar] [CrossRef]
- van de Belt, H.; Neut, D.; Uges, D.R.; Schenk, W.; van Horn, J.R.; van der Mei, H.C.; Busscher, H.J. Surface roughness, porosity and wettability of gentamicin-loaded bone cements and their antibiotic release. Biomaterials 2000, 21, 1981–1987. [Google Scholar] [CrossRef]
- Vaishya, R.; Chauhan, M.; Vaish, A. Bone cement. J. Clin. Orthop. Trauma 2013, 4, 157–163. [Google Scholar] [CrossRef] [PubMed]
- Frutos Cabanillas, P.; Díez Peña, E.; Barrales-Rienda, J.M.; Frutos, G. Validation and in vitro characterization of antibiotic-loaded bone cement release. Int. J. Pharm. 2000, 209, 15–26. [Google Scholar] [CrossRef]
- Anagnostakos, K.; Kelm, J. Enhancement of antibiotic elution from acrylic bone cement. J. Biomed. Mater. Res. Part B Appl. Biomater. 2009, 90, 467–475. [Google Scholar] [CrossRef]
- Baker, A.S.; Greenham, L.W. Release of gentamicin from acrylic bone cement. Elution and diffusion studies. J. Bone Jt. Surg. 1988, 70, 1551–1557. [Google Scholar] [CrossRef]
- De, S.; Vazquez, B. The effect of cross-linking agents on acrylic bone cements containing radiopacifiers. Biomaterials 2001, 22, 2177–2181. [Google Scholar]
- Nussbaum, D.A.; Gailloud, P.; Murphy, K. The chemistry of acrylic bone cements and implications for clinical use in image-guided therapy. J. Vasc. Interv. Radiol. 2004, 15, 121–126. [Google Scholar] [CrossRef]
- Topoleski, L.D.; Ducheyne, P.; Cuckler, J.M. A fractographic analysis of in vivo poly(methyl methacrylate) bone cement failure mechanisms. J. Biomed. Mater. Res. 1990, 24, 135–154. [Google Scholar] [CrossRef]
- Mircioiu, C.; Voicu, V.; Anuta, V.; Tudose, A.; Celia, C.; Paolino, D.; Fresta, M.; Sandulovici, R.; Mircioiu, I. Mathematical Modeling of Release Kinetics from Supramolecular Drug Delivery Systems. Pharmaceutics 2019, 11, 140. [Google Scholar] [CrossRef]
- Pascual, B.; Gurruchaga, M.; Ginebra, M.P.; Gil, F.J.; Planell, J.A.; Goñi, I. Influence of the modification of P/L ratio on a new formulation of acrylic bone cement. Biomaterials 1999, 20, 465–474. [Google Scholar] [CrossRef]
- Haas, S.S.; Brauer, G.M.; Dickson, G. A characterization of polymethylmethacrylate bone cement. J. Bone Jt. Surg. 1975, 57, 380–391. [Google Scholar] [CrossRef]
- Saha, S.; Pal, S. Mechanical properties of bone cement: A review. J. Biomed. Mater. Res. 1984, 18, 435–462. [Google Scholar] [CrossRef]
- Belkoff, S.M.; Sanders, J.C.; Jasper, L.E. The effect of the monomer-to-powder ratio on the material properties of acrylic bone cement. J. Biomed. Mater. Res. 2002, 63, 396–399. [Google Scholar] [CrossRef]
- Lautenschlager, E.P.; Jacobs, J.J.; Marshall, G.W.; Meyer, P.R., Jr. Mechanical properties of bone cements containing large doses of antibiotic powders. J. Biomed. Mater. Res. 1976, 10, 929–938. [Google Scholar] [CrossRef] [PubMed]
- Lautenschlager, E.P.; Marshall, G.W.; Marks, K.E.; Schwartz, J.; Nelson, C.L. Mechanical strength of acrylic bone cements impregnated with antibiotics. J. Biomed. Mater. Res. 1976, 10, 837–845. [Google Scholar] [CrossRef] [PubMed]
- Dunne, N.J.; Hill, J.; McAfee, P.; Kirkpatrick, R.; Patrick, S.; Tunney, M. Incorporation of large amounts of gentamicin sulphate into acrylic bone cement: Effect on handling and mechanical properties, antibiotic release, and biofilm formation. Proc. Inst. Mech. Eng. Part H J. Eng. Med. 2008, 222, 355–365. [Google Scholar] [CrossRef] [PubMed]
- Liawrungrueang, W.; Ungphaiboon, S.; Jitsurong, A.; Ingviya, N.; Tangtrakulwanich, B.; Yuenyongviwat, V. In vitro elution characteristics of gentamicin-impregnated Polymethylmethacrylate: Premixed with a second powder vs. liquid Lyophilization. BMC Musculoskelet. Disord. 2021, 22, 5. [Google Scholar]

| Basic Bone Cement Composition (Liquid/Powder Ratio = 100%) | Antibiotic (0.1 g) | |||
|---|---|---|---|---|
| Powder Components (4 g) | Liquid Components (2 mL) | |||
| PMMA (w/w %) | 88.5% | MMA | 98.5% | Gentamicin |
| BaSO4 (w/w %) | 10.0% | DMPT | 1.5% | |
| BPO (w/w %) | 1.5% | |||
| Parameter | Liquid/Powder % | Radiopacifier | Initiator | Antibiotic | |||||||||||||||
|---|---|---|---|---|---|---|---|---|---|---|---|---|---|---|---|---|---|---|---|
| Sample Groups | LP | LP | LP | LP | R | R | R | R | R | I | I | I | I | I | G | G | G | G | G |
| 70 | 85 | 100 | 115 | 10 | 15 | 20 | 25 | 30 | 0.5 | 1 | 1.5 | 2 | 2.5 | 0.05 | 0.1 | 0.2 | 0.3 | 0.4 | |
| L/P ratio (%) | 70 | 85 | 100 | 115 | 100 | 100 | 100 | ||||||||||||
| Liquid (mL) | 1.4 | 1.7 | 2 | 2.3 | 2 | 2 | 2 | ||||||||||||
| Powder (g) | 4 | 4 | 4 | 4 | |||||||||||||||
| PMMA (%) | 88.5 | 88.5 | 83.5 | 78.5 | 73.5 | 68.5 | 89.5 | 89 | 88.5 | 88 | 87.5 | 88.5 | |||||||
| BaSO4 (%) | 10 | 10 | 15 | 20 | 25 | 30 | 10 | 10 | |||||||||||
| BPO (%) | 1.5 | 1.5 | 0.5 | 1 | 1.5 | 2 | 2.5 | 1.5 | |||||||||||
| Gentamicin (g) | 0.1 | 0.1 | 0.1 | 0.05 | 0.1 | 0.2 | 0.3 | 0.4 | |||||||||||
| Bacteria 1 ZOI (mm) | Pseudomonas aeruginosa | Staphylococcus aureus | Escherichia coli |
|---|---|---|---|
| Day 1 | 30.63 ± 2.36 mm | 25.00 ± 1.00 mm | 28.88 ± 2.84 mm |
| Day 2 | 22.75 ± 4.27 mm | 18.75 ± 2.06 mm | 19.75 ± 0.96 mm |
| Day 3 | 21.00 ± 5.23 mm | 17.50 ± 3.00 mm | 18.25 ± 3.10 mm |
| Day 7 | 17.75 ± 3.20 mm | 14.38 ± 1.25 mm | 16.67 ± 3.82 mm |
| Day 14 | 12.00 ± 1.08 mm | 9.88 ± 1.18 mm | 10.75 ± 2.22 mm |
| Sample Group (Liquid/Powder Ratio) | LP70 (70%) | LP85 (85%) | LP100 (100%) | LP115 (115%) |
|---|---|---|---|---|
| Total% Porosity | 72.3 | 19.6 | 12 | 14.6 |
| Median Pore Diameter (µm) | 11.2 | 7 | 4.2 | 4.7 |
| Sample Group (Radiopacifier Ratio) | R10 (10%) | R15 (15%) | R20 (20%) | R25 (25%) | R30 (30%) |
|---|---|---|---|---|---|
| Total% Porosity | 12 | 18.1 | 18.5 | 24.7 | 23.1 |
| Median Pore Diameter (µm) | 4.2 | 5.3 | 7.4 | 8.5 | 13.9 |
| Sample Group (BPO Ratio) | I0.5 (0.5%) | I1 (1%) | I1.5 (1.5%) | I2 (2%) | I2.5 (2.5%) |
|---|---|---|---|---|---|
| Total% Porosity | 18.4 | 19.5 | 12 | 15.5 | 15.1 |
| Median Pore Diameter (µm) | 7 | 6.3 | 4.2 | 5.6 | 5 |
| Sample Group (Doses of Gentamicin) | G0.05 (0.05 g) | G0.1 (0.1 g) | G0.2 (0.2 g) | G0.3 (0.3 g) | G0.4 (0.4 g) |
|---|---|---|---|---|---|
| Total% Porosity | 11.6 | 12 | 27.9 | 26 | 39.3 |
| Median Pore Diameter (µm) | 4 | 4.2 | 4.9 | 12.7 | 14.9 |
Publisher’s Note: MDPI stays neutral with regard to jurisdictional claims in published maps and institutional affiliations. |
© 2021 by the authors. Licensee MDPI, Basel, Switzerland. This article is an open access article distributed under the terms and conditions of the Creative Commons Attribution (CC BY) license (https://creativecommons.org/licenses/by/4.0/).
Share and Cite
Chen, I.-C.; Su, C.-Y.; Nien, W.-H.; Huang, T.-T.; Huang, C.-H.; Lu, Y.-C.; Chen, Y.-J.; Huang, G.-C.; Fang, H.-W. Influence of Antibiotic-Loaded Acrylic Bone Cement Composition on Drug Release Behavior and Mechanism. Polymers 2021, 13, 2240. https://doi.org/10.3390/polym13142240
Chen I-C, Su C-Y, Nien W-H, Huang T-T, Huang C-H, Lu Y-C, Chen Y-J, Huang G-C, Fang H-W. Influence of Antibiotic-Loaded Acrylic Bone Cement Composition on Drug Release Behavior and Mechanism. Polymers. 2021; 13(14):2240. https://doi.org/10.3390/polym13142240
Chicago/Turabian StyleChen, I-Cheng, Chen-Ying Su, Wei-Han Nien, Tzu-Tien Huang, Chang-Hung Huang, Yung-Chang Lu, Yu-Jen Chen, Gwo-Che Huang, and Hsu-Wei Fang. 2021. "Influence of Antibiotic-Loaded Acrylic Bone Cement Composition on Drug Release Behavior and Mechanism" Polymers 13, no. 14: 2240. https://doi.org/10.3390/polym13142240
APA StyleChen, I.-C., Su, C.-Y., Nien, W.-H., Huang, T.-T., Huang, C.-H., Lu, Y.-C., Chen, Y.-J., Huang, G.-C., & Fang, H.-W. (2021). Influence of Antibiotic-Loaded Acrylic Bone Cement Composition on Drug Release Behavior and Mechanism. Polymers, 13(14), 2240. https://doi.org/10.3390/polym13142240

